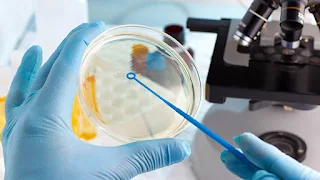

Um estudo na Austrália observou que um remédio antiparasita, usado geralmente para tratar verminoses, foi capaz de inibir o crescimento do novo coronavírus Sars-CoV-2 em cultura de células, controlando o micro-organismo em 48 horas.
O estudo foi liderado pela Monash University e feito em parceria com o Doherty Institute of Infection and Immunity, e foi publicado na revista Antiviral Research, da Elsevier, no último dia 3.
Os cientistas observaram que uma dose único da droga Ivermectin foi capaz de combater o SARS-CoV-2. Atualmente, a Ivermectin está disponível no mercado em todo o mundo.
“Nós descobrimos que mesmo uma dose única pode essencialmente remover todo o RNA viral em 48 horas e que mesmo em 24 horas há uma redução significativa”, disse a doutora Kylie Wagstaff, que liderou o estudo.
Os cientistas alertam que, apesar do potencial de efetividade do medicamento observado em laboratório, ele ainda não pode ser usado com segurança em seres humanos infectados com o novo coronavírus, tampouco em casos de automedicação. O estudo precisa ser continuado com testes clínicos e testes em humanos para concluir a efetividade da droga em doses seguras para humanos.
Em outros estudos, o Ivermectin já se mostrou eficiente contra outros vírus, como HIV, Dengue, Influenza e Zika vírus.
Outros estudos
Na Universidade Tsinghua, de Pequim, um grupo de cientistas chineses isolou vários anticorpos que diz serem “extremamente eficientes” para impedir a capacidade do novo coronavírus de entrar nas células, o que pode ser útil tanto para tratar como para prevenir a Covid-19.
Já um novo estudo publicado por pesquisadores da Universidade de Pittsburgh, nos Estados Unidos, traz um projeto de vacina contra o novo coronavírus que já foi avaliado pela comunidade científica. A pesquisa mostra avanços promissores na criação de uma vacina contra o vírus ao atacar as células ACE-2, às quais o novo coronavírus se liga ao corpo humano para se reproduzir e atacar o organismo, causando sintomas como febre, dores no corpo e dificuldade de respirar.
Exame